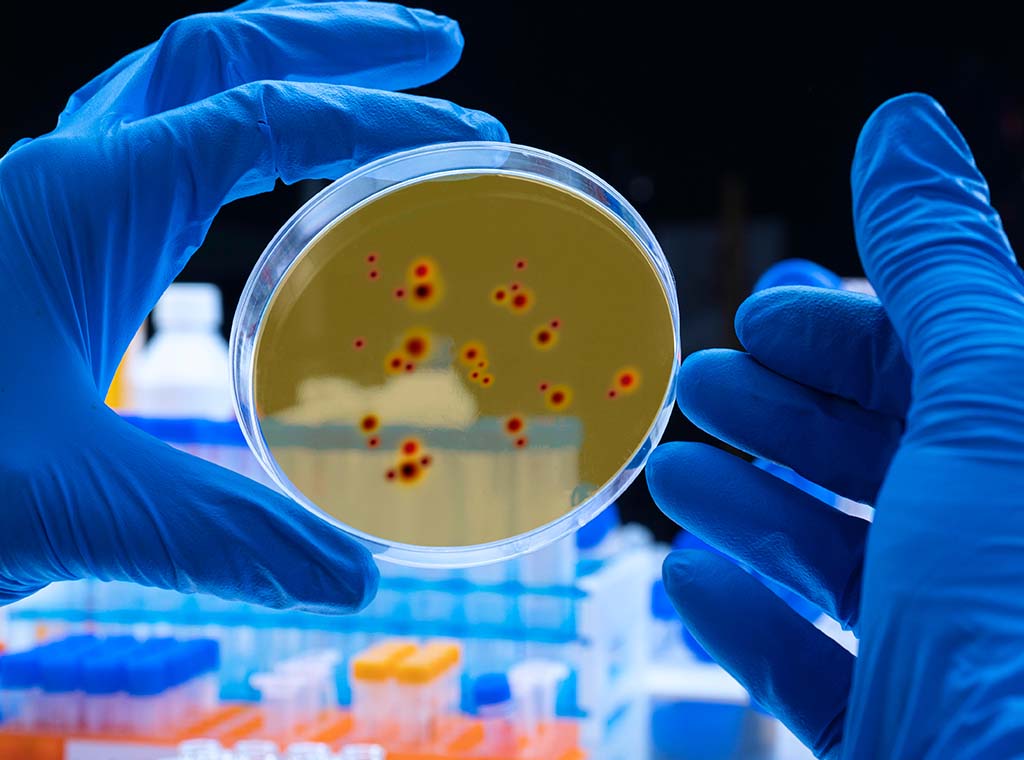
Biochemistry II (Plant & Animal)

Advanced Certificate in Applied Animal Science
Learn the biology, taxonomy, anatomy and physiology of wildlife, pets and farm animals. Understand the relevance and applications for science with animal manage...

Advanced Certificate in Applied Plant Science
Learn to work with plants in horticulture, environmental management, forestry or science. Understand the science that underpins modern plant based industries, a...

Advanced Certificate in Applied Sciences
Study applied sciences online. Understand the application of chemistry, human biology, animal biology and plant biology in agriculture, horticulture, environmen...

Advanced Certificate in Botany
A comprehensive and advanced course of study in botanical science. Understand the chemistry, anatomy and physiology of plants as a foundation to work in plant s...

Anatomy II (Human)
Deepen your understanding of human anatomy. Learn more about surface, regional and systemic anatomy, and radiographic, diagnostic anatomy and cytology.

Artificial Intelligence
Learn about how A.I. can improve productivity if used properly, but how that requires critical evaluation of outputs and skills beyond just knowing how to ask a...

Biochemistry I (Animal and Human)
Study biochemistry with this online self-paced course. Learn the foundations of chemistry, the composition of animal cells, important cellular processes, and mo...

Biochemistry I (Plants)
Study biochemistry - the chemistry of living things - focusing on plants. Foundation course for anyone working with plants: from gardeners to research assistant...
Biochemistry II (Plant & Animal)
Intermediate level online biochemistry course. Study the structure and dynamics of proteins, the role of enzymes and hormones, and more.

Biochemistry III (Animal Processes)
Learn about biochemistry and its application to animal systems, such as DNA structure, energy processing, and more.

Biochemistry III (Plant Processes)
Expand your understanding of plant biochemical processes. A valuable course for horticulturists, farmers, plant scientists or anyone involved in growing plants.

Botany I (Plant Physiology And Taxonomy)
Study botany and learn about plant physiology (how they grow and flower) and taxonomy (the naming system). This course is relevant to botanists, scientists, hor...

Botany II (Plant Growth and Development)
Learn the principles of plant physiology and their practical applications in this advanced botany course. A valuable course to understand plant growth.

Cell Biology
Study cell biology by distance education. Learning the physiology and anatomy of living cells, tissues, the nucleus, cytoplasm, and more.

Certificate In Applied Science
Study Certificate in Applied Science online. Specialise in plant, animal, environmental or health. Work in science-related jobs with minimal formal study.

Certificate in Plant Science
This course provides a broad understanding of how plants function and grow, covering botany, ecology and pathology. It also builds on your ability to solve prob...

Climate Science
Learn how climate functions to better understand weather conditions and patterns. A useful course for farmers, environmentalists, land managers, and a foundat...

Drone Technology
Online course to help you understand how drones work, the different types and various applications they can have in different industries.

Electronics
Learn the theory and applications for electronics - a foundation for working with electrical systems from battery operated devices and computers to audio visual...

Engineering II - Engineering Applications
Study engineering applications online. Learn surveying, drainage, earth moving, environmental control in greenhouses, applications in agriculture and horticultu...

Environmental Chemistry
Develop your understanding of chemistry, the impact chemicals have on ecosystems, and how this relates to the environment as a whole.

Genetic Applications
Learn how genetics can be applied to animal, plant industries and health sciences. The course covers inheritance, genetic technologies, epigenetics, genetic eng...

Gut Microbiome Management (Human)
Life changing online course teaches management of the gut microbiome for superior wellbeing. Learn to manage the gut microbiome for improved health outcomes, st...

Human Anatomy & Physiology (Human Biology 1A)
Online foundation course in human biology. Learn about cells & tissues, the skeleton, muscles, nerves and more. Work in health science or fitness.

Introduction to Forensics
Learn about the scope and nature of forensic science - how modern science can be applied to law, to aid with solving crimes. A foundation course with relevance ...

Medical Terminology
Study medical language at home to understand the structure of medical terms. Learn by distance education to work as a medical administrator, medical secretary o...

Microbiology
Study microbiology and its application to human and animal health. Excellent as a bridging course, an introduction to science, this course is also useful for th...

Nanotechnology
Learn how microscopic particles are manipulated to develop nanoscale materials for diverse cutting edge applications across a wide range of scientific fields; f...

Physics II (Applied Physics)
Physics forms a foundation for many professions such as engineering, construction and architecture. In this course, we will discuss electricity, power generatio...

Physiology II (Human)
Study human physiology for applied health science, medicine, or fitness; learning by distance education, about Menbrane transport, Cellular metabolism, Cellula...

Plant Conservation
Study plant conservation online. Professional development course for anyone working in or with a passion for plants, the environment, land management and conser...

Plant Ecology
Study botanical science for a career or job with plants and environmental management; learn how plants interact with each other and their environment.

Plant Taxonomy
Learn how plants are scientifically named and classified - binomial system, ranks of classification, plant descriptions, plant keys, phylogeny, morphology, reco...

Soil and Water Chemistry
Study soil and water chemistry. Learn about the complex interactions of soil and water in the environment and their applications in agriculture, health and envi...

Statistics
Online course in statistics. Learn statistical methods. Understand data collection, distributions, central tendency, trends. Determine z-scores, t-scores, corre...







